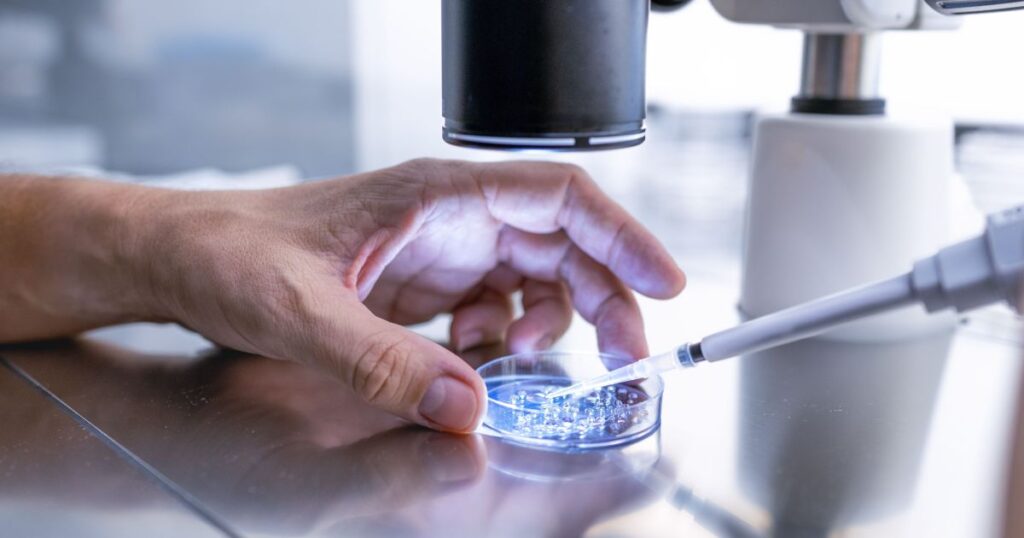

Como Funciona a Doação de Óvulos?
Thank you for reading this post, don't forget to subscribe!A doação de óvulos é um procedimento no qual uma mulher doa seus óvulos (gametas) para outra que não consegue obtê-los por conta própria, devido a condições como insuficiência ovariana. Esses óvulos doados são então utilizados em um ciclo de reprodução assistida para tentar engravidar a receptora. No Brasil, a legislação estabelece que a doação deve ser voluntária e altruísta, ou seja, a doadora não pode receber pagamento pelos óvulos doados.
O Processo de Doação Compartilhada
Existe a modalidade de doação compartilhada, onde a doadora que deseja congelar seus óvulos ou precisa realizar a fertilização in vitro (FIV) pode doar parte de seus óvulos. Nesse caso, a receptora arca com os custos do tratamento, total ou parcialmente, e recebe os óvulos doados, enquanto a doadora utiliza os óvulos restantes para seus próprios fins reprodutivos.
Quem Pode se Beneficiar da Doação de Óvulos?
Diversas condições podem levar à necessidade da doação de óvulos, incluindo:
Falência Ovariana Prematura: Quando os ovários param de funcionar antes dos 40 anos.
Baixa Reserva Ovariana ou Má Qualidade Oocitária: Diminuição na quantidade e/ou qualidade dos óvulos, frequentemente associada à idade avançada.
Doenças Genéticas Transmissíveis: Casais com risco de transmitir doenças genéticas graves aos seus descendentes.
Falhas Repetidas de FIV: Mulheres que passaram por múltiplos ciclos de FIV sem sucesso, possivelmente devido à qualidade dos óvulos.
Ausência dos Ovários: Casos de agenesia ovariana (ausência congênita) ou ooforectomia bilateral (remoção cirúrgica).
Mulheres Solteiras ou Casais Homoafetivos: Que necessitam de gametas femininos para a concepção.
Critérios Para Ser Doadora de Óvulos
Os critérios para ser doadora são rigorosos, visando proteger tanto a saúde da doadora quanto a do futuro bebê:
Idade: A doadora deve ter entre 18 e 37 anos.
Saúde Geral: É necessário apresentar excelente estado de saúde física e mental, sem histórico de doenças genéticas hereditárias, infecciosas transmissíveis ou doenças crônicas.
Avaliação Médica: Inclui exames ginecológicos completos, ultrassonografia pélvica para avaliar os ovários e a reserva ovariana, além de exames de sangue para rastrear infecções e doenças genéticas.
Anonimato: A doação é anônima, garantindo que a identidade da doadora não seja revelada à receptora e vice-versa.
Coleta dos Óvulos e Transferência Embrionária
A coleta dos óvulos, também conhecida como punção folicular, é realizada em ambiente hospitalar ou clínica de reprodução assistida, sob sedação ou anestesia leve. Utilizando um ultrassom transvaginal para guiar uma agulha fina, os folículos são aspirados individualmente, e o líquido folicular contendo os óvulos é coletado.
Após a coleta, os óvulos são avaliados em laboratório por um embriologista. Geralmente, não são os óvulos doados que são transferidos para a receptora, mas sim os embriões resultantes da fecundação. A transferência embrionária é realizada sem anestesia, com os embriões sendo colocados no útero por um cateter fino e flexível, guiado por ultrassom abdominal.
Após a transferência, a receptora deve seguir cuidados específicos, como repouso relativo, suporte hormonal e acompanhamento médico.
Conclusão
A doação de óvulos representa uma importante ferramenta para casais e mulheres que enfrentam desafios para engravidar. É crucial buscar informações detalhadas sobre o processo, os critérios envolvidos e as opções disponíveis, como a doação compartilhada. Ao considerar essa alternativa, é fundamental procurar uma clínica de reprodução assistida com profissionais qualificados e experientes, que possam oferecer o suporte necessário em todas as etapas do tratamento.
FAQ
1. A doadora de óvulos é remunerada?
Não, no Brasil a doação de óvulos é um ato voluntário e altruísta, não sendo permitida a remuneração financeira pela doação.
2. Qual a idade máxima para ser receptora de óvulos?
Geralmente, a idade máxima para ser receptora de óvulos é de 50 anos, mas essa idade pode variar conforme a clínica e as condições de saúde da mulher.
3. O receptor tem acesso à identidade da doadora?
Não, a doação de óvulos no Brasil é anônima, o que significa que a identidade da doadora e da receptora são mantidas em sigilo.
Se você está considerando a doação de óvulos como uma opção para realizar o sonho da maternidade ou paternidade, entre em contato conosco para agendar uma consulta e obter mais informações sobre o processo. Nossa equipe está pronta para te ajudar em cada etapa!
Fonte: https://www.cnnbrasil.com.br